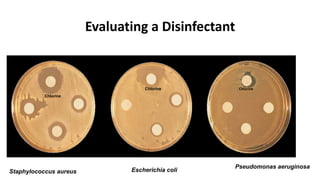
Evaluating a Disinfectant
Chlorine
Chlorine Chlorine
Staphylococcus aureus Escherichia coli
Pseudomonas aeruginosa
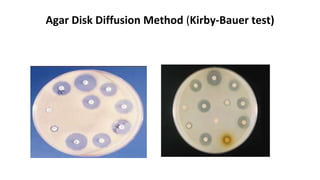
Agar Disk Diffusion Method (Kirby-Bauer test)

1. The document discusses various chemical biocides used as antiseptics, disinfectants, and preservatives. These include alcohols, quaternary ammonium compounds, biguanides, aldehydes, parabens, and others.
2. Methods for measuring antimicrobial activity are described, including broth dilution methods to determine minimum inhibitory concentration (MIC), agar diffusion methods, and kill curve techniques.
3. Factors that influence biocide activity are discussed, along with mechanisms of action, ideal properties of antiseptics and disinfectants, and methods for evaluating preservative efficacy.